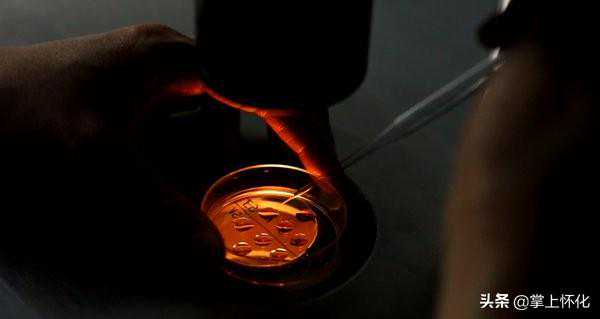

怀化市妇幼保健院首例试管婴儿孕39周顺利娩出掌上怀化讯2月29日凌晨,怀化市妇幼保健院产房传出一声响亮的啼哭。怀化市妇幼保健院首例试管婴儿孕39周顺利娩出。这也是是怀化市妇幼保健院“试管婴儿”项目开展......

怀化市妇幼保健院首例试管婴儿孕39周顺利娩出
掌上怀化讯2月29日凌晨,怀化市妇幼保健院产房传出一声响亮的啼哭。怀化市妇幼保健院首例试管婴儿孕39周顺利娩出。这也是是怀化市妇幼保健院“试管婴儿”项目开展后第一位出生的助孕宝宝,为怀化市卫生健康事业发展又添上了浓墨重彩的一笔。

医院领导看望宝宝和宝妈
2019年2月,怀化市妇幼保健生殖医学科顺利通过“试管婴儿”技术(IVF-ET/ICSI)全国生殖专家组试运行评审,成为湘西山片区首家取得开展体外受精-胚胎移植、卵胞浆内单精子显微注射项目的医疗机构。3月,婚后多年未孕的甘芳(化名)夫妇来到怀化市妇幼保健院生殖科,科主任周永来主任医师结合其病例和相关检查报告,综合的分析与评估,建议两人通过“试管婴儿”技术为其助孕来实现他们的孕育梦。
到哪里做“试管婴儿”,甘芳夫妇身边亲朋好友多次建议他们到省里或北京、上海的大医院。但在与周永来及生殖科医务人员接触的过程中,甘芳夫妇深深感受到了这个团队严谨、负责、贴心,坚定地选择怀化市妇幼保健院。
胚胎实验室人员在进行胚胎培养操作
治疗过程中,医院将他们纳入怀化市妇幼保健院首批“爱心助孕”项目,为其减免了两万余元的试管治疗费用,夫妻双方从术前检查到胚胎移植完成,整个过程仅花费了一万余元。
5月的一天,移植后的14天,甘芳夫妇试管婴儿成功妊娠。在整个妊娠期间,怀化市妇幼保健院生殖科医护人员对其进行了全方位照料和无微不至的照顾,为其母子安全保驾护航。
据悉,该院自正式开展试管助孕技术还不到一年时间,已经实施了120多个试管治疗周期,成功率为58.7%,达到了国内先进水平。

周永来介绍,2020年怀化市妇幼保健院将还有数十位“助孕宝宝”降生,同时成功助孕的不孕不育家庭数量也在增加。医院致力于“优生优育一站式”服务,将让更多的不孕家庭在家门口就能“怀得上”“生得出”“育的好”。(田雨鹭向凯)